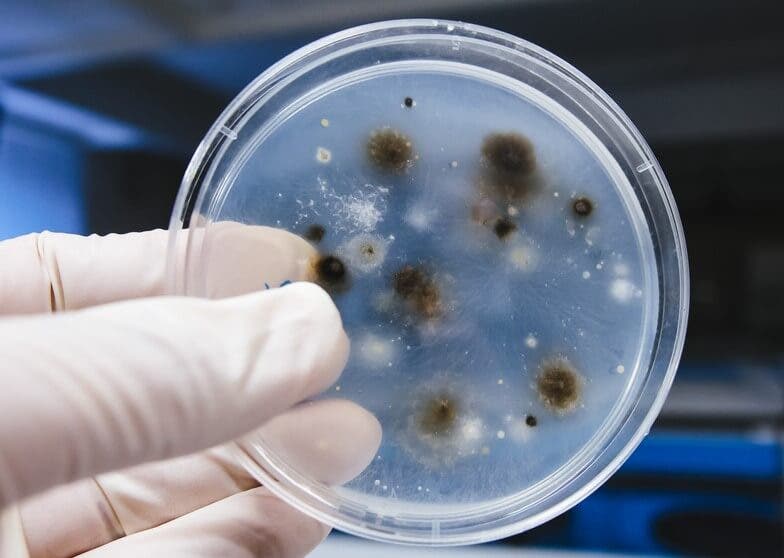

Blastomicosis


Escrito y verificado por la médico Maricela Jiménez López
La blastomicosis es una infección que ocurre por la inhalación de esporas de un hongo que afecta principalmente a los pulmones. Si se disemina puede afectar al sistema nervioso, los huesos y otros órganos.
El Blastomyces dermatitidis es un hongo dimorfo presente en la naturaleza. Que sea un hongo dimorfo implica que en su ciclo vital adopta forma de levadura y de micelo:
- En primer lugar, forma de levadura con yemas en los tejidos.
- En segundo lugar, forma de micelo en el suelo y la madera.
Este tipo de hongo aparece sobre todo en climas templados y húmedos, cerca de ríos o lagos y en la madera. Por esta razón, afecta principalmente a trabajadores rurales, como agricultores y campesinos.
Por otra parte, este tipo de hongo también afecta a mamíferos domésticos; es decir, a perros y gatos.
Patogenia
Al inhalar las esporas, estas viajan hacia los pulmones. Por lo tanto, el sistema inmune se activa. Las esporas pueden provocar lesiones en los bronquios y diseminarse por todo el pulmón. No obstante, si las defensas del individuo no están afectadas, esta infección se resuelve sin presentar sintomatología alguna.
En cambio, debido a que es un hongo dimorfo, las esporas pueden transformarse en levaduras en los tejidos gracias a la temperatura corporal. Esto produce que tengan resistencia a la fagocitosis. Como consecuencia, se reproducen en los lóbulos inferiores, con cambios supurativos y formación de granulomas.
Una vez que afecta al pulmón, puede afectar a otros órganos, principalmente huesos y piel. Por otra parte, cuando el contagio es por inoculación cutánea, aparece una zona enrojecida o eritema denominado chancro o complejo primario, que puede evolucionar dando lesiones granulomatosas en la piel.
¿No lo sabías? Coccidioidomicosis o fiebre de San Joaquín
Clínica
Las formas clínicas son variadas, la más común es la blastomicosis pulmonar. Otras variantes menos recuentes con la blastomicosis cutánea y la blascomicosis diseminada.
Blastomicosis pulmonar
El 50% son asintomáticas y solo del 1 al 5% presentan síntomas, cuya gravedad depende del estado inmunitario del paciente. Cuando aparecen, los síntomas son similares a una neumonía:
- En primer lugar, tos.
- En segundo lugar, fiebre leve.
- Por último, disnea o dificultad para respirar.
La evolución puede conllevar dolor torácico y más raramente, derrame pleural. Las lesiones pulmonares son variables, desde nódulos pequeños hasta grandes áreas de necrosis que comprometen de forma grave la función pulmonar. En función de su evolución, podemos diferenciarla en:
- Blastomicosis aguda
Esta tiene unos síntomas pulmonares muy marcados asociados a fatiga, sudoración y pérdida de peso. Puede complicarse de forma importante a las 2-3 semanas de la infección.
- Blastomicosis crónica
En ella aparece una calcificación de las lesiones pulmonares, invasión de la pleura y a veces de la pared torácica.
Blastomicosis cutánea primaria

La blastomicosis cutánea primaria es una forma poco frecuente de infección. La localización depende de la inoculación, principalmente en la cara y las extremidades.
A las dos semanas de la inoculación del hongo, aparece una lesión enrojecida. La evolución de complejo primario formará lesiones elevadas y de mayor tamaño con afectación de los ganglios linfáticos regionales.
A veces las lesiones se ulceran o adquieren forma verrucosa. Suelen tender a la curación espontánea sin tratamiento.
Visita este artículo: Cómo identificar si tienes hongos en los pies
Blastomicosis diseminada
Entidad rara producida por la diseminación del hongo desde el foco pulmonar hacia otros órganos por vía sanguínea. Las afecciones principales son la cutánea (hay que diferenciarla de la blastomicosis cutánea primaria) y la ósea:
- Blastomicosis cutánea secundaria: A veces es la primera manifestación clínica de la infección.
- Aparece una pequeña lesión elevada que evoluciona a nódulo rojo-violáceo.
- En la evolución tiende a reblandecerse, formando úlceras o abscesos.
- Blastomicosis ósea: Afecta principalmente a las vértebras y las costillas. Las lesiones van a producir una inflamación del periostio (capa dura que recubre los huesos), con fibrosis y lisis del hueso.
La blastomicosis diseminada puede afectar a casi todos los órganos, incluyendo entre los comunes las meninges, el cerebro, aparato genitourinario y próstata.
Diagnóstico de la blastomicosis
Las técnicas diagnóstica se van a basar en demostrar la existencia del hongo. Hay distintas pruebas:
- Por un lado, pruebas radiológicas: Rayos X, tomografía computarizada o resonancia magnética. Útiles en afectación pulmonar y ósea.
- Por otro lado, un examen directo del hongo.
- También hay pruebas inmunológicas.
- Biopsia (útil en las blatomicosis cutáneas).
- Serología.
- Por último, cultivo.
Tratamiento
Una vez determinado el hongo, el tratamiento consistirá en la utilización de fármacos antimicóticos. La elección de uno y otro, dosis y duración del tratamiento dependerá de la sintomatología y grado de afectación del paciente.
Los fármacos más utilizados son itraconazol, fluconazol y anfotericina B. Generalmente, cuando la infección es leve o moderada, se prefiere itraconazol. Sin embargo, en presencia de infecciones más graves que amenazan la vida del paciente, se utiliza anfotericina B intravenosa.
En conclusión
La blastomicosis es una enfermedad pulmonar que puede complicarse y afectar a otros órganos de forma grave. Ante cualquier síntoma, se debe acudir al especialista para que valore el diagnóstico y el posible tratamiento.
Todas las fuentes citadas fueron revisadas a profundidad por nuestro equipo, para asegurar su calidad, confiabilidad, vigencia y validez. La bibliografía de este artículo fue considerada confiable y de precisión académica o científica.
- Rezusta, A., Gil, J., & Rubio, M. (2013). Micosis Importadas. Sociedad Española de Enfermedades Infecciosas y Microbiología.
- Laniado-Laborín, R. (2007). Coccidioidomicosis y otras micosis endémicas en México. Revista Iberoamericana de Micología. https://doi.org/http://dx.doi.org/10.1016/S1130-1406(07)70051-7
- Serrano, M. (1943). Blastomicosis. Revista Medicina y Cirugía. https://doi.org/10.1016/j.ijrobp.2004.12.062
Este texto se ofrece únicamente con propósitos informativos y no reemplaza la consulta con un profesional. Ante dudas, consulta a tu especialista.









